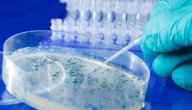
استخدامات البلازميد صورة مقال استخدامات البلازميد

محتويات

نظرية زحزحة القارات
تُعرف نظرية زحزحة القارات أو ما يُعرف بالانجراف القاري (بالإنجليزية: Continental drift) بأنّها حركة القارات الأفقية واسعة المدى بالنسبة لبعضها البعض وبالنسبة للمحيطات خلال حقبة جيولوجية واحدة أو حقبات مُتعاقبة،[١] وقد تمّ تطوير هذه النظرية في العام 1912م من قِبل عالم الجيوفيزياء والأرصاد الجوية الألماني ألفريد فيغنر، حيث فسّرت النظرية كيفية أخذ القارات لموقعها الحالي على سطح الكرة الأرضية.[٢][٣]
يرى فيغنر أنّ جميع القارات كانت كتلةً واحدةً كبيرةً من اليابسة قبل حوالي 240 مليون عام أطلق عليها اسم بانجيا "Pangaea" والتي تعني في اليونانية كلّ الأراضي، ثمّ انقسمت هذه الكتلة خلال العصر الجوراسي إلى جزأين رئيسيين أُطلق عليهما لوراسيا وغندوانا، قبل أن تتحرّك هذه الكُتل وتنقسم إلى مواقعها الحالية وذلك في نهاية العصر الطباشيري، وقد وضع فيغنر نظريته هذه بناءً على العديد من النظريات السابقة التي تناولت الحركة الأفقية للقارات، بالإضافة إلى بعض الملاحظات العلمية الخاصة التي وضعها بنفسه؛ كملاحظته لوجود أحافير حيوانية ونباتية وتكوينات صخرية مُتشابهة في قارات مُختلفة.[٢][٣]
دلائل نظرية زحزحة القارات
وضع فيغنر نظرية زحزحة القارات بناءً على العديد من الدلائل المختلفة، والتي شملت دراسة الأحافير النباتية والتراكيب الصخرية في العديد من القارات، فاكتشف وجود أحافير خاصة بنباتات استوائية لا تستطيع العيش إلّا في بيئة رطبة ودافئة في القطب الشمالي وتحديداً في منطقة سفالبارد النرويجية، وقد دلّ وجود مثل هذه الأحافير على أنّ سفالبارد كانت في يوم من الأيام ذات مناخ مداريّ غير مشابه للمناخ الحالي للقطب الشمالي.[٤]
دعم فيغنر نظريته بدلائل أخرى تتمثّل في إيجاده لبعض السلاسل الجبلية المنفصلة والتي كانت ترتبط ببعضها البعض سابقاً كجبال الأبالاش في شرق الولايات المتحدة الامريكية وجبال كالدونيان في سكوتلندا، ومن الأدلة الأخرى التي دعمت نظريته التطابق التام للساحل الشرقي لقارة أمريكا الجنوبية مع الساحل الغربي لقارة أفريقيا، الأمر الذي يُشير إلى أنّهما كانتا كتلةً واحدةً من اليابسة.[٤]
معارضة نظرية زحزحة القارات
كان هناك مُعارضة شديدة لنظرية فيغنر ولأسباب مُختلفة، حيث كان أولها أنّ نظرية فيغنر جاءت بمفهوم مُغاير ومُضاد لعلم الجيولوجيا المعروف في ذلك الزمان، فضلاً عن أنّ نظريته افتقرت لتقديم تفسير منطقي لماهيّة القوى التي أدّت إلى تحريك القارات وزحزحتها عن بعضها البعض، فقد طرح فيغنر تفسيرين مختلفين لهذا الأمر؛ وهما أنّ مصدر هذه القوى ناتج عن جاذبية المدّ والجزر للشمس والقمر، أو أنّها ناتجة عن قوة الطرد المركزي بفعل دوران الأرض، إلّا أنّ هذين التفسيرين كانا ضعيفين حيث تمّ دحضهما من قِبل معارضي نظرية فيغنر، فقد رأوا أنّ هذه القوى غير كافية لتحريك القارات.[٥] [٣]
شكّلت بعض التناقضات الموجودة في نظرية زحزحة القارات سبباً لرفضها، ومن ذلك اكتشاف بعض أنواع الحفريات الموجودة في آسيا في مناطق خارج الهند وهذا الأمر يعني أنّ هذا النوع من الحفريات غير محصور بما يُعرف بغندوانا، وهو ما يتعاكس مع ما يراه مؤيّديو نظرية زحزحة القارات.[٣][٥]
رافق ظهور نظرية زحزحة القارات ظهور نظريات أخرى لتفسير حركتها حيث أشارت بعضها إلى أنّ جميع قارات العالم كانت مرتبطةً بجسور بريّة غرقت في البحر نتيجة عمليات التبريد التي أدّت إلى تقلّص طبقات الأرض، وهذا الأمر هو ما يُفسّر وجود أحافير مُتشابهة في أنحاء مُختلفة من قارات العالم بحسب ما أشارت إليه تلك النظريات، ولكن فيغنر ردّ على هذه النظرية ورفضها مؤكّداً أنّ القارات تحرّكت بالفعل وانقسمت، ومن النظريات الأخرى التي جابهت ظهور نظرية زحزحة القارات هي تلك التي فسّرت انتقال الأحافير الموجودة في القطب الشمالي من خلال التيارات المائية الدافئة، ورغم أنّ هذه النظرية تمّ دحضها في الوقت الحالي إلّا أنّها شكّلت أحد أسباب رفض العالم لنظرية زحزحة القارات عند ظهورها.[٣]
تطوّر نظرية زحزحة القارات لنظرية الصفائح التكتونية
وضع ألفريد فيغنر نظرية زحزحة القارات في العام 1912م حيث كانت معرفة الكثير عن قيعان البحار والمحيطات أمراً غير مُمكن، وخلال فترة الحرب العالمية الثانية تطوّرت عدّة تقنيات تمّ استخدامها لأغراض علمية؛ كتقنيات رسم الخرائط البحرية، والسبر المائي، وغيرها من التقنيات الأخرى كالتعدين والتنقيب عن النفط، وبفضل ظهور هذه التقنيات أجرى العلماء دراسات على التصدعات والتلال المحيطية، والرواسب الموجودة في قاع المحيط، والمجالات المغناطيسية، والأنشطة الجيولجية كالبراكين والزلازل، فكلّ تلك الدراسات والقياسات والملاحظات أدّت إلى فهم أكبر للعمليات التي تحدث داخل الأرض وعلى سطحها.[٦]
قدّم هاري هيس في العام 1963م نظريةً تقوم على فكرة أنّ القشرة الأرضية لقاع المحيط تنشأ في منطقة السلاسل الجبلية في وسط المحيطات، ولكنّ هذه القشرة سرعان ما يتمّ إرجاعها إلى منطقة الستار الأرضي نتيجةً لتمدد قيعان المحيطات، وبعد إجراء هاري هيس لتجارب علمية اقترح أنّ السبب في تمدد قيعان المحيطات قد يعود إلى حركة تيارات الحمل الموجودة في الستار الأرضي، وقد ارتكز هيس في طرحه هذا على العمر الحديث بشكل نسبي للصخور الموجودة في قيعان المحيطات، حيث إنّ عمر بعض هذه الصخور لا يزيد عن 200 ألف عام، كما استند هيس على قياسات سرعة الزلازل في منطقة غلاف موري (بالإنجليزية: asthenosphere) على عمق يتراوح بين 100 إلى 200 كيلومتر، حيث رأى هيس بأنّ ذلك الغلاف يتكوّن نتيجة الانصهار الجزئي لأجزاء من القشرة الأرضية.[٦]
أكّدت الأبحاث الجيولوجية الأمريكية في الستينيات من القرن العشرين نظرية تمدد قاع البحر، وفي العام 1963م أشار كلّ من إيمري وشيلي إلى أنّه لا بدّ من الجمع بين علم الجيولوجيا البحرية وعلم الجيولوجيا الأرضية لتشكيل فهم أفضل لدراسة جميع العمليات الجيولوجية التي تجري على قشرة الأرض، وبالفعل حدث ذلك في نهاية عقد الستينيات من القرن العشرين حيث بدأ علماء الجيولوجيا بالجمع بين نظريتي زحزحة القارات وتمدد قاع البحر لإنشاء آلية جديدة لدراسة الجيولوجيا الأرضية والبحرية ليظهر ما يُعرف بنظرية الصفائح التكتونية (بالإنجليزية: Tectonic plates)، وقد تطرّقت هذه النظرية إلى مناقشة جميع جوانب القشرة الأرضية، والصخور وظروف تكوينها، والأنشطة الجيولوجية المختلفة المُتعلقة بها،[٦] وقد تمّ قبول هذه النظرية، ونتيجةً لقيامها على بعض ما أورده فيغنر في نظرية زحزحة القارات فقد تمّ الاعتراف بفضله في فهم حقيقة حركة القارات.[٧]
أهمية زحزحة القارات
تُعتبر نظرية زحزحة القارات من النظريات المهمّة بالنسبة للبشرية ويعود ذلك إلى العديد من الأمور، ومنها ما يأتي:[٨]
- تغيّر المناخ العالمي: وذلك نتيجة حركة القارات وزحزحتها، وهذا التغيّر يؤثّر على التطوّر البشري على سطح الأرض.
- جعل الحيطات بمثابة عازل يفصل بين العديد من أشكال الحياة: فذلك يجعل لموقع القارات أهميةً بالغةً في تطوّر أشكال الحياة عليها.
- تبريد سطح الأرض: فعندما تحدث حركة القارات فوق أحد الأقطاب أو عندما تتسبّب هذه الحركة بتكوين الجبال تتساقط الثلوج التي تعكس حرارة الشمس إلى الفضاء، الأمر الذي يؤدّي إلى تبريد سطح الأرض.[٩]
- تقليل نسبة غاز ثاني أكسيد الكربون الموجود في الغلاف الجوي: حيث يُحرّر الجليد المُتكون بفعل تساقط الثلوج الناتج عن حركة القارات المعادن من الصخور، ممّا يؤدّي إلى حملها عبر الأنهار إلى البحار و تفاعلها مع ثاني أكسيد الكربون الموجود في الهواء، وبالتالي تقليل نسبته في الغلاف الجوي وتقليل نسبة غازات الدفيئة.[٩]
- التأثير على الرياح: وذلك نتيجة تشكّل الجبال بسبب زحزحة القارات.[٩]
- انتقال المياه من محيط إلى آخر.[٩]
مجال الأرض المغناطيسي وزحزحة القارات
تمتلك الأرض مجالاً مغناطيسياً يتكوّن من خطوط للقوة تجعل إبرة البوصلة تتحرّك بشكل دائم إلى اتجاه القطب الشمالي للأرض، وتتقاطع خطوط القوة المُكوّنة للمجال المغناطيسي الأرضي مع سطح الأرض بزوايا مختلفة تختلف تبعاً للموقع على سطح الكرة الأرضية، وتُعرف بزوايا الميل المغناطيسي حيث تكون عند القطبين المغناطيسيين للأرض تُساوي 90 درجة، بينما تُساوي صفراً عند خط الاستواء المغناطيسي، ومن خلال الميل المغناطيسي والزاوية التي يُشكّلها يُمكن تحديد الموقع على سطح الأرض نسبةً إلى القطبين المغناطيسيين.[١٠]
تمّ التوصّل في خمسينات القرن المُنصرم إلى أنّ المجالات الموجودة داخل المعادن المغناطيسية تتخذ اتجاهاً موازياً لأيّ مجال مغناطيسي خارجي وذلك عندما تكون حرارتها تحت ما يُعرف بدرجة حرارة كوري (بالإنجليزية: Curie temperature)، ونظراً لاحتواء الصخور على المعادن فإنّه يُمكن تحديد اتجاه المجال المغناطيسي الصادر عن تلك المعادن ما دام أنّها لم تبلغ درجة حرارة كوري، ومن هنا أصبح مُمكناً دراسة المغناطيسية الحركية للأرض.[١٠]
بيّنت الدراسات التي تمّ إجراؤها على موقع القطب المغناطيسي للأرض أنّ موقعه قد تغيّر على مرّ الزمان، حيث أشارت نتائج الدراسات على صخور ذات أعمار مُختلفة إلى احتوائها على مجالات مغناطيسية مُختلفة اختلفت تبعاً للقطب المغناطيسي الموجود في كلّ عصر، وتقود هذه الاختلافات في المجالات المغناطيسية إلى استنباطين أولهما غير مقبول وهو وجود أكثر من قطب مغناطيسي للأرض في الأزمنة المُنصرمة، وثانيهما وهو الوارد أنّ هذا الاختلاف في المغناطيسية وُجد تبعاً لاختلاف موقع القارات بالنسبة لبعضها البعض عبر الزمن وهو ما يؤيّد نظرية زحزحة القارات.[١٠]
المراجع
- ↑ Adam Augustyn (13-3-2019), "Continental drift"، www.britannica.com, Retrieved 6-1-2020. Edited.
- ^ أ ب Becky Oskin (19-12-2017), "Continental Drift, Sea Floor Spreading and Plate Tectonics: Theory & Definition"، www.livescience.com, Retrieved 6-1-2017. Edited.
- ^ أ ب ت ث ج Lisa Marder (24-7-2019), "The Continental Drift Theory: Revolutionary and Significant"، www.thoughtco.com, Retrieved 6-1-2019. Edited.
- ^ أ ب "Continental drift", www.nationalgeographic.org, Retrieved 6-1-2020. Edited.
- ^ أ ب Ramesh Chander (1999), Wegener and his Theory of Continental Drift , India: RESONANCE, Page 30،32. Edited.
- ^ أ ب ت Eoin H. Macdonald (2007), "Nature and history of gold"، www.sciencedirect.com, Retrieved 6-1-2020. Edited.
- ↑ Pablo A.Pellegrini (4-2-2019), "Styles ofThought ontheContinental Drift Debate"، www.researchgate.net, Retrieved 6-1-2020. Edited.
- ↑ D.R. KHANNA (2004), Human Evolution, New Delhi: Discovery Publishing House, Page 46. Edited.
- ^ أ ب ت ث ًWyken seagrave (2012), History of the Universe, United Kingdom: Penny Press Ltd, Page 0. Edited.
- ^ أ ب ت Prof. Stephen A. Nelson (27-8-2015), "Continental Drift"، https://www.tulane.edu/~sanelson/eens1110/pltect.htm, Retrieved 6-1-2020. Edited.